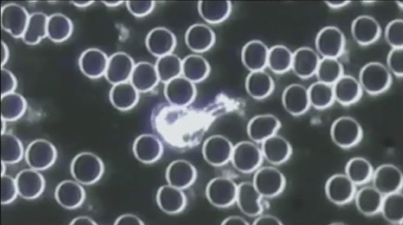
Cellular cleanse - Ideal blood cells

These photos amaze me! They are real examples of blood cells under microscope and they show how ISAGENIX’s Cleanse for Life® and IsaLean™ Shakes can have amazing results at restoring our immune systems as well as healthy weight loss in just 11 days.

Our body’s immune systems are our most important defense against illness and disease. Our bodies have 60 trillion cells that replicate, divide & renew every 7 years (except for brain cells & certain nerve cells). We are a body of re-generation. When we feed the body the necessary nutritional building blocks, the miracle of the body will work. With Cleanse for Life® ISAGENIX’s Master Formulator, John Anderson also created a way to rid substances that do not belong in the body. While the body cleanses naturally, it is constantly bombarded by impurities from our food, air and water. These impurities lodge in our large filters (colon, liver, kidney, lymphatic system & cardiovascular system) and in our cells.
The liver performs over 100 different functions and the lymphatic system is like a vacuum system that opens and closes miles of vessels pulling out metabolic fluids and waste. Cleanse for Life® cleanses the whole body at the cellular level.
The 11 day regiment would usually consist of 2 Shake days, 2 Cleanse days, 5 Shake days, and finishing off with 2 more Cleanse days.
A Shake day would be replacing 2 conventional meals with 2 IsaLean™ Shakes plus one healthy low-glycemic, 400-600 calorie meal as well as 2 snacks (More calories can be consumed once in weight maintenance). The IsaLean® shakes are nutrient rich and contain superior un-denatured whey and milk proteins. (A dairy-free version exists) They are more than a shake, it’s a meal replacement (240 cal.) with its proteins (24 g), energy-fueling carbohydrates (8 g fiber), good fats, and 23 vitamins and minerals per serving.
A Cleanse days would comprise of 4 deep cleanse servings as well as 4 to 6 Isagenix® snacks servings throughout the day. The Cleanse for Life® dietary supplement contains plant botanicals and antioxidants which grab the toxins out of the fat cells and flush them out. Unlike harsh laxative cleanses, this dietary supplement is scientifically developed to nourish the body with the vital nutrients it needs while ridding the body of impurities. Once toxins are removed, the body naturally burns off the extra fat cells that are no longer needed to protect the body.
Amazing!
These statements have not been evaluated by the Food and Drug Administration. The ISAGENIX products are not intended to diagnose, treat, cure, or prevent any disease.